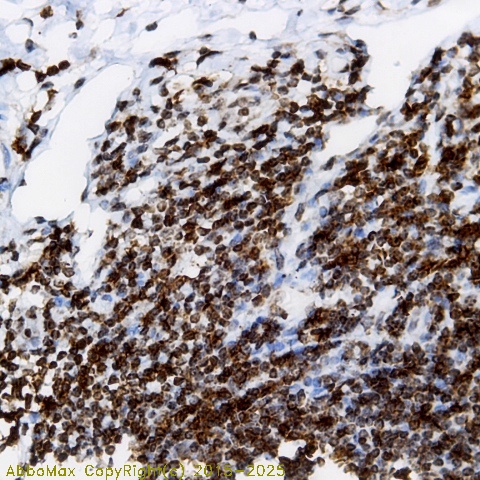

Ki-67
MKI67; antigen KI-67; proliferation-related Ki-67 antigen
 Download Product PDF
Download Product PDF
 MSDS Download Product PDF
MSDS Download Product PDF
Antigen Preparation
A synthetic peptide derived from human Ki-67 protein
Background
"Ki-67, a proliferation marker is a nuclear protein that is associated with and may be necessary for cellular proliferation. It can be used as a biomarker with Bcl-2 (an apoptosis inhibitor), P53 and Pax 2 for immunohistostaining in carcinomas diagnosis. The differences in the immunocytochemical expression of those markers are correlated to the results with tumor grade and stage for a further accurate diagnosis. "
PURIFICATION
The Rabbit IgG is purified by Epitope Affinity Purification
|
SPECIFICITY
"This antbody recognizes human, mice and rat Ki-67 protein. The other species not tested."
|
FORMULATION
This affinity purified antibody is supplied in sterile Phosphatebuffered saline (pH7.2) containing antibody stabilizer
|
STORAGE
The antibodies are stable for 24 months from date of receipt when stored at –20oC to –70oC. The antibodies can be stored at 2oC-8oC for three month without detectable loss of activity. Avoid repeated freezing-thawing cycles.
|
Applications/Suggested Working Dilutions
|
|
|
Immunoprecipitation
2-5 µg/ml
|
|
Flow cytometry
Not tested
|